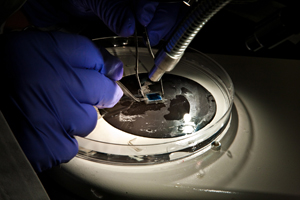

This article is archived and only made available for historical reference. If you’d like to discover UCSF’s most recent advances in research, education and patient care, please visit the UCSF News Center.
Archive: UCSF unveils model for implantable artificial kidney to replace dialysis
UCSF researchers today unveiled a prototype model of the first implantable artificial kidney, in a development that one day could eliminate the need for dialysis.
The device, which would include thousands of microscopic filters as well as a bioreactor to mimic the metabolic and water-balancing roles of a real kidney, is being developed in a collaborative effort by engineers, biologists and physicians nationwide, led by Shuvo Roy, PhD, in the UCSF Department of Bioengineering and Therapeutic Sciences.
The treatment has been proven to work for the sickest patients using a room-sized external model developed by a team member in Michigan. Roy’s goal is to apply silicon fabrication technology, along with specially engineered compartments for live kidney cells, to shrink that large-scale technology into a device the size of a coffee cup. The device would then be implanted in the body without the need for immune suppressant medications, allowing the patient to live a more normal life.
“This device is designed to deliver most of the health benefits of a kidney transplant, while addressing the limited number of kidney donors each year,” said Roy, an associate professor in the UCSF School of Pharmacy who specializes in developing micro-electromechanical systems (MEMS) technology for biomedical applications. “This could dramatically reduce the burden of renal failure for millions of people worldwide, while also reducing one of the largest costs in U.S. healthcare.”
The team has established the feasibility of an implantable model in animal models and plans to be ready for clinical trials in five to seven years.
End-stage renal disease, or chronic kidney failure, affects more than 500,000 people per year in the United States alone, and currently is only fully treated with a kidney transplant. That number has been rising between 5-7 percent per year, Roy said, in part because of the kidney damage associated with diabetes and hypertension.
Yet transplants are difficult to obtain: a mere 17,000 donated kidneys were available for transplant last year, while the number of patients on the transplant waiting list currently exceeds 85,000, according to the Organ Procurement ant Transplant Network.
Roughly 350,000 patients are reliant on kidney dialysis, Roy explained, which comes at a tremendous cost. The Medicare system alone spends $25 billion on treatments for kidney failure – more than 6 percent of the total budget – while the disease affects only 1 percent of Medicare recipients, he said. That cost includes almost $75,000 per patient each year for dialysis, according to the U.S. Renal Data System.
Dialysis also takes a human toll. A typical dialysis schedule is three sessions per week, for 3 to 5 hours per session, in which blood is pumped through an external circuit for filtration. This is exhausting for patients and only replaces 13 percent of kidney function, Roy said. As a result, only 35 percent of patients survive for more than 5 years.
With the limited supply of donors, that means thousands of patients die each year waiting for a kidney.
The implantable device aims to eradicate that problem. The two-stage system uses a hemofilter to remove toxins from the blood, while applying recent advances in tissue engineering to grow renal tubule cells to provide other biological functions of a healthy kidney. The process relies on the body’s blood pressure to perform filtration without needing pumps or an electrical power supply.
The project exemplifies the many efforts under way at UCSF to build collaborations across scientific disciplines that accelerate the translation of academic research into real solutions for patients, according to Mary Anne Koda-Kimble, PharmD, dean of the UCSF School of Pharmacy.
“This is a perfect example of the work we are doing at UCSF to address some of the most critical medical issues of our time, both in human and financial costs,” Koda-Kimble said. “This project shows what can be accomplished by teams of scientists with diverse expertise, collaborating to profoundly and more quickly improve the lives of patients worldwide.”
The creation of the Department of Bioengineering and Therapeutic Sciences – a joint department in the UCSF schools of Pharmacy and Medicine – was itself an effort to promote translational research at UCSF by forming collaborations across biomedical specialties. Roy is also a founding faculty member of the UCSF Pediatric Device Consortium, which aims to accelerate the development of innovative devices for children health, and a faculty affiliate of the California Institute for Quantitative Biosciences (QB3) at UCSF.
His team is collaborating with 10 other teams of researchers on the project, including the Cleveland Clinic where Roy initially developed the idea, Case Western Reserve University, University of Michigan, Ohio State University, and Penn State University.
The first phase of the project, which has already been completed, focused on developing the technologies required to reduce the device to a size that could fit into the body and testing the individual components in animal models. In the second and current phase, the team is doing the sophisticated work needed to scale up the device for humans. The team now has the components and a visual model and is pursuing federal and private support to bring the project to clinical use.
UCSF is a leading university dedicated to promoting health worldwide through advanced biomedical research, graduate-level education in the life sciences and health professions, and excellence in patient care.
Related Links
- Kidney Project on Facebook
- UCSF Department of Bioengineering and Therapeutic Sciences
- • Artificial Kidney: Medicine’s Next Big Thing? Ivanhoe News, Feb 16, 2011
- • UCSF team working on artificial kidney, San Francisco Chronicle, Nov 16, 2010
- • Building artificial kidneys, KQED Forum with Michael Krasney, Nov 17, 2010